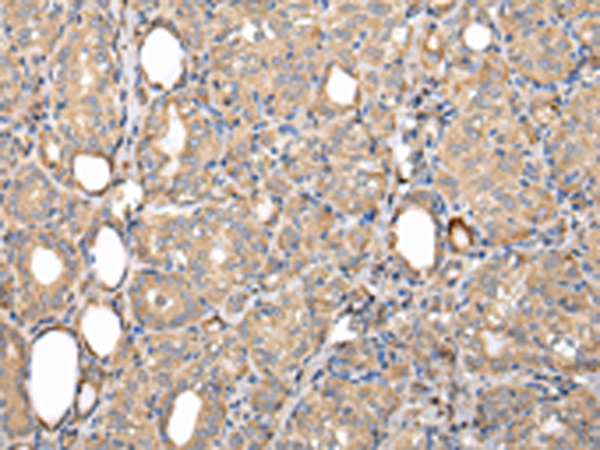

中文名稱: 兔抗SERPINA7多克隆抗體
英文名稱: Anti-SERPINA7 rabbit polyclonal antibody
別 名: TBG
抗 原: SERPINA7
儲(chǔ) 存: 冷凍(-20℃)
宿 主: Rabbit
反應(yīng)種屬: Human
相關(guān)類別: 一抗
標(biāo) 記 物: Unconjugate
克隆類型: rabbit polyclonal
技術(shù)規(guī)格
|
Background: |
There are three proteins including thyroxine-binding globulin (TBG), transthyretin and albumin responsible for carrying the thyroid hormones thyroxine (T4) and 3,5,3'-triiodothyronine (T3) in the bloodstream. This gene encodes the major thyroid hormone transport protein, TBG, in serum. It belongs to the serpin family in genomics, but the protein has no inhibitory function like many other members of the serpin family. Mutations in this gene result in TGB deficiency, which has been classified as partial deficiency, complete deficiency, and excess, based on the level of serum TBG. Alternatively spliced transcript variants encoding different isoforms have been found, but the full-length nature of these variants has not been determined. |
|
Applications: |
ELISA, IHC |
|
Name of antibody: |
SERPINA7 |
|
Immunogen: |
Full length fusion protein |
|
Full name: |
serpin peptidase inhibitor, clade A (alpha-1 antiproteinase, antitrypsin), member 7 |
|
Synonyms: |
TBG |
|
SwissProt: |
P05543 |
|
ELISA Recommended dilution: |
2000-5000 |
|
IHC positive control: |
Human liver cancer and Human prostate cancer |
|
IHC Recommend dilution: |
25-100 |
購(gòu)物車
購(gòu)物車 幫助
幫助
 021-54845833/15800441009
021-54845833/15800441009
